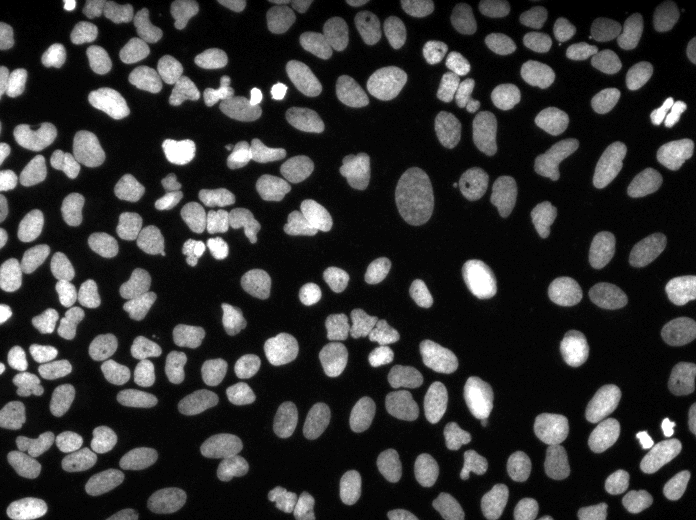
023_img.png

- SHA256:
- f8c9fc4fd20499ec60fcc3ea002a5a31f187b8465d9bb2a27798924f53712304
- Pointer size:
- 131 Bytes
- Size of remote file:
- 345 kB
- Xet hash:
- ae9bd375cdd9c00bb597f5b587b74e51939daec119720b53dc9f85935039b2c6
·
·
Xet efficiently stores Large Files inside Git, intelligently splitting files into unique chunks and accelerating uploads and downloads. More info.